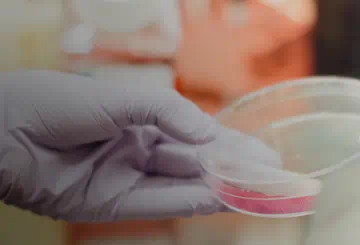

For all media inquiries, please contact amgenmediarelations@amgen.com.
The below contact information is for members of the news media only. For all other requests, please contact Amgen's main number at 805-447-1000 or visit Amgen.com/contact-us for more information.